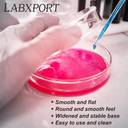

LABXPORT Glass Reusable Petri Dish (100 mm Pack of 1)
Share
LABXPORT Glass Reusable Petri Dish (100 mm Pack of 1)
Be the first to Review this product
Special price
₹228
₹399
42% off
Available offers
T&C
Delivery
Check
Enter pincode
Delivery by11 Dec, Thursday
?
View Details
Services
- Cash on Delivery available?
Seller
Description
This borosilicate glass petri dish is a must-have for professionals, educators, and science enthusiasts. Designed for use in laboratories, schools, and home experiments, the dish is made from premium borosilicate glass, known for its high durability and resistance to thermal shock and chemicals. With a precisely fitted lid and 90mm standard size, it’s perfect for culturing microorganisms, growing fungi, observing reactions, or even crafting and candle-making. Safe for autoclaves and ovens, this dish is both reusable and easy to sterilize, making it an eco-friendly and cost-effective lab solution.
Read More
Specifications
In The Box
| Pack of |
|
General
| Brand |
|
| Model Number |
|
| Material |
|
| Usage Type |
|
| Net Quantity |
|
Additional Features
| Lid Included |
|
Dimensions
| Inner Diameter |
|
| Outer Diameter |
|
| Weight |
|
Be the first to ask about this product
Safe and Secure Payments.Easy returns.100% Authentic products.
Back to top